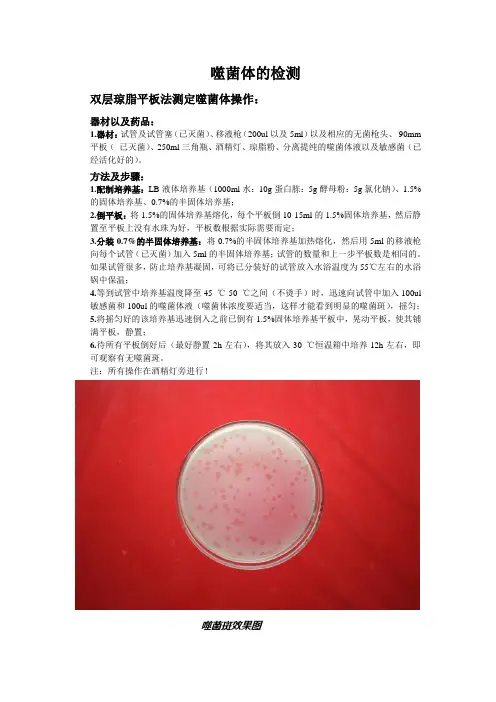

噬菌体分离
- 格式:doc
- 大小:32.50 KB
- 文档页数:2

噬菌体分离纯化的原理和步骤1. 噬菌体简介好啦,大家,今天我们来聊聊一个有趣又神奇的东西,叫做噬菌体。
听起来像是外星人发明的玩意儿,其实它是一种专门攻击细菌的病毒,简直是细菌界的“灭霸”。
它们在微观世界中偷偷摸摸地工作,悄无声息地解决那些惹人烦的细菌问题。
咱们身边的细菌可不少,有的对我们有益,但有的却是个十足的“败类”。
这时候,噬菌体就像是细菌的天敌,真是太酷了!2. 分离纯化的意义2.1 为何要分离纯化噬菌体?那么,为什么我们要把噬菌体分离和纯化呢?首先,想象一下,如果你在一个大杂烩中找一颗珍珠,那可是相当困难的。
所以我们得把这些小家伙从杂乱的环境中“捞”出来,单独让它们站到聚光灯下。
这样一来,我们就可以更好地研究它们,了解它们是怎么攻击细菌的,有助于开发新的治疗手段,像是抗生素的替代品。
2.2 纯化的重要性再者,纯化的过程就像是给噬菌体洗澡,洗去那些多余的脏东西,只留下最纯粹的样子。
这样才能确保我们研究的数据准确,不然的话,可能会被一些“干扰分子”搞得一团糟。
想想,如果你的咖啡里多了一勺盐,那可就毁了整杯了,不是吗?3. 分离纯化的步骤3.1 收集样本接下来,我们来说说具体步骤。
第一步,得收集样本。
你可以从土壤、水源,甚至是一些腐烂的食物中找到细菌和噬菌体。
这可不是随便捞的,咱得选那些“鱼塘”丰富的地方。
想象一下,像在一片荒野中寻找“金矿”,可是比喻中的“金矿”得小心翼翼,别让细菌给我们添乱。
3.2 培养细菌收集好样本后,我们要把这些细菌培养起来。
通常用一些培养基,就像细菌的“自助餐”。
让它们在温暖的环境中肆意生长,像是细菌的“欢乐派对”。
可是咱可不能忘了,噬菌体也会趁机来“捣乱”,所以这时得时刻盯着它们的动态。
3.3 噬菌体分离一旦细菌培养得差不多了,就可以进行分离了。
这里可以用过滤的方法,把细菌和噬菌体分开。
想象一下,像是在过筛子,把沙子和金子分开,真是一场“筛沙子”的大比拼。
然后把留下来的液体提取出来,这里就大功告成了,噬菌体终于登场了。

噬菌体基因组提取方法全文共四篇示例,供读者参考第一篇示例:噬菌体是一类侵染细菌的微生物,其基因组提取方法是研究噬菌体性质和功能的关键步骤之一。
噬菌体基因组提取的目的是获取噬菌体DNA,以便进行后续的分子生物学研究和应用。
本文将系统介绍噬菌体基因组提取的方法及其应用。
一、样品采集在进行噬菌体基因组提取之前,首先需要对需要研究的噬菌体进行样品采集。
样品可以来源于各种环境中的细菌样品,例如水体、土壤、动植物表面等。
在采样时需要注意样品的保存和运输条件,避免对噬菌体DNA的破坏。
二、细胞裂解细胞裂解是基因组提取的第一步,其目的是破坏噬菌体细胞壁和细胞膜,释放出噬菌体DNA。
传统的裂解方法包括化学裂解和物理裂解。
化学裂解使用蛋白酶、SDS等化学试剂破坏细胞结构,物理裂解则是利用高温、高压、超声波等手段使细胞破裂。
近年来,随着生物技术的发展,还出现了新的细胞裂解方法,如离心裂解、酶切裂解等,这些方法具有高效、低成本、易操作等优点。
三、蛋白质和RNA的去除在提取得到的细胞裂解液中,除了目标的噬菌体DNA外还会存在大量的蛋白质、RNA等杂质。
这些杂质会影响后续的DNA纯化和测序分析,因此需要进行去除。
通常采用蛋白酶和RNase酶对裂解液进行处理,将蛋白质和RNA降解分解,然后通过差速离心或柱层析等方法将杂质分离。
四、DNA的纯化经过蛋白质和RNA的去除后,得到的裂解液中含有目标噬菌体DNA。
为了获得纯净的DNA样品,需要进行DNA的纯化。
常见的DNA纯化方法包括酚/氯仿提取、硅胶柱纯化、磁珠分选等。
这些方法可以有效地去除残留的杂质,得到高质量的噬菌体DNA。
五、DNA的测序分析最后一步是对提取得到的噬菌体DNA进行测序分析。
目前,常用的DNA测序技术包括Sanger测序、next-generation sequencing(NGS)和第三代测序技术等。
这些技术可以对噬菌体的基因组结构、功能基因等进行深入的研究和分析,为噬菌体的应用研究提供重要的数据支持。

细菌的噬菌体分型实验二细菌的噬菌体分型第一部分肠杆菌科噬菌体的分离、纯化与增殖噬菌体广泛存在于自然界。
凡是有细菌存在的地方,一般都能找到相应的噬菌体。
例如,土壤、肥料、腐烂有机物、粪便和阴沟污水等常是各种细菌的栖息地,从中能分离到相应的噬菌体。
从自然界分离某一噬菌体需要经过以下步骤:培养宿主菌(或叫做敏感菌);采集含噬菌体的样品;噬菌体富集培养;制备噬菌体裂解液;验证噬菌体的存在;噬菌体的纯化;噬菌体的增殖;噬菌体的效价测定和保存。
下面以大肠杆菌噬菌体为例详细介绍噬菌体的分离和纯化方法。
1( 噬菌体的分离(1)制备菌悬液:取大肠杆菌斜面一支,加4ml无菌水洗下菌苔,制成菌悬液。
(2)增殖培养:于10ml三倍浓缩的肉膏蛋白胨液体培养基的三角烧瓶(1支5ml吸管)中,加入污水样品20ml(1支5ml吸管)与大肠杆菌悬液0.2ml(1支1ml吸管),37?培养12h,24h以增殖噬菌体。
(3)制备裂解液:将以上增殖的混合培养液2500r/min离心15 min(1支5ml吸管)。
将上清液倒入无菌平皿,针管抽取液体,在针栓式滤器上过滤除菌。
所得滤液倒入灭菌瓶内,取少量滤液作无菌试验,即将它接入牛肉膏蛋白胨培养液中(1支5ml吸管、1支1ml吸管、1支无菌带帽华氏管),置于37?培养过夜,以作无菌检查。
(4)噬菌体确证试验:滤液经37?培养过夜,若无细菌生长则表明已经彻底除菌。
需进一步证明噬菌体的存在。
于已烘干的肉膏蛋白胨琼脂平板(平皿1个)表面加一滴大肠杆菌悬液(1支1ml吸管),再用灭菌玻璃涂布器将菌液涂布成均匀的一薄层。
放置数分钟,待琼脂表面干燥,在菌层的表面布点5个,7个,每点滴加上述滤液1小滴(1ml枪1把和枪头10个),同时选择其中一点不加滤液只滴加一小滴生理盐水为对照,再放置数分钟,使液滴被琼脂吸干。
倒置平板,37?培养过夜。
次日观察结果,若平板上滴加滤液的部位出现噬菌斑,而在对照滴中处无噬菌斑,则表明该滤液中肯定含有大肠杆菌相应噬菌体。
噬菌体的检测双层琼脂平板法测定噬菌体操作:器材以及药品:1.器材:试管及试管塞(已灭菌)、移液枪(200ul以及5ml)以及相应的无菌枪头、90mm 平板(已灭菌)、250ml三角瓶、酒精灯、琼脂粉、分离提纯的噬菌体液以及敏感菌(已经活化好的)。
方法及步骤:1.配制培养基:LB液体培养基(1000ml水:10g蛋白胨:5g酵母粉:5g氯化钠)、1.5%的固体培养基、0.7%的半固体培养基;2.倒平板:将1.5%的固体培养基熔化,每个平板倒10-15ml的1.5%固体培养基,然后静置至平板上没有水珠为好,平板数根据实际需要而定;3.分装0.7%的半固体培养基:将0.7%的半固体培养基加热熔化,然后用5ml的移液枪向每个试管(已灭菌)加入5ml的半固体培养基;试管的数量和上一步平板数是相同的。
如果试管很多,防止培养基凝固,可将已分装好的试管放入水浴温度为55℃左右的水浴锅中保温;4.等到试管中培养基温度降至45 ℃-50 ℃之间(不烫手)时,迅速向试管中加入100ul 敏感菌和100ul的噬菌体液(噬菌体浓度要适当,这样才能看到明显的噬菌斑),摇匀;5.将摇匀好的该培养基迅速倒入之前已倒有1.5%固体培养基平板中,晃动平板,使其铺满平板,静置;6.待所有平板倒好后(最好静置2h左右),将其放入30 ℃恒温箱中培养12h左右,即可观察有无噬菌斑。
注:所有操作在酒精灯旁进行!噬菌斑效果图培养噬菌体的方法:一. 液体培养法1. 将指定之寄主细菌以液体培养法于适当温度下培养,一般培养16~24小时。
2. 将噬菌体原液100 μl 与寄主细菌悬浮液300 μl均匀混合,静置15分钟使其感染。
3. 将混合液接种至含10 ml新鲜液体培养基的试管中,于适当温度下振荡培养约8~24小时,培养时间依噬菌体之不同而异。
4. 将培养液移入离心管中,以10,000 rpm (5,000 g)离心10分钟,以沉淀寄主细菌。
5. 将上清液移至新管中,以0.22μm孔径之过滤器(filter)去除残余菌体,即得不含寄主细菌之噬菌体原液。

噬菌体的分离纯化及一步生长曲线的绘制前言噬菌体是以细菌为寄主的一类非细胞微生物。
目前对于噬菌体的研究大多数集中在人和动物传染性疾病的防治方面,在环境的治理方面的研究报道较少,因此我们试图分离纯化污水中的噬菌体,掌握其生物学性质,应用所得噬菌体处理、净化生活污水,减少生活污水中病原性细菌的危害。
本研究以从小鹅中提取的大肠杆菌为宿主菌,从污水中分离噬菌体并进行纯化,最后绘制一步生长曲线。
1材料与方法1.1材料1.1.1菌种及样品菌种:从小鹅中提取的大肠杆菌,由老师提供。
污水来源:主要来自于农大出水口。
1.1.2试剂1mmol/L CaCl2溶液1.1.3试剂的配制(1) 液体牛肉膏培养基:胰蛋白胨5g,牛肉膏1.5 g,NaCl 2.5g,加H2O至500mL,pH7.4,121 ℃20min高压灭菌。
(2) 3×牛肉膏培养液:胰蛋白陈3g,牛肉膏0.9g,NaCl 1.5g,加H2O 至100mL,pH7.4,121 ℃20min高压灭菌。
(3) 固体牛肉膏培养基:每100mL液体牛肉膏培养基加入1.5g琼脂粉,121 ℃20min高压灭菌。
(4) 半固体牛肉膏培养基:每100mL液体牛肉膏培养基加入0.7g琼脂粉,121℃20min高压灭菌。
1.1.4主要仪器电热恒温培养箱(SHEL·LAB)、电热恒温水温箱(HHW21·Cu600,XMTD)、恒温摇床(中国科学院武汉科学仪器厂)、通风柜(M·TFG-A)、医用净化工作台(苏净集团安泰公司)、台式离心机(eppendorf)、台式高速冷冻离心机(BECKMAN COULTER)、超低温冰箱(Forma Scientific)、YM50全自动不锈钢立式电热蒸汽消毒器、针头式细菌过滤器、0.22μm微孔滤膜(上海市新亚净化器件厂)、微量移液器(GILSON)、UVette(Eppendorf)。
1.2方法1.2.1噬菌体的分离1.2.1.1摇菌老师提供的大肠杆菌液加入5mL1×牛肉膏液体培养基,混合后,37℃振荡(120rpm)14h,此时大肠杆菌达到了对数生长期,取出4℃保存。

㊀2021,37(4)中国人兽共患病学报C h i n e s e J o u r n a l o f Z o o n o s e sD O I :10.3969/j.i s s n .1002-2694.2021.00.039 疾病防治1株粘质沙雷氏菌噬菌体的分离和鉴定肖小平,陈依玲,张仁利国家自然科学基金(N o .31700148)和深圳 三名 病媒传染病防治研究项目(N o .S Z S M 201611064)联合资助通讯作者:张仁利,E m a i l :r e n l i z h a n g s z c d c @a l i yu n .c o m ;O R C I D :0000G0001G5037G1035作者单位:深圳市疾病预防控制中心病原生物研究所,深圳㊀518055摘㊀要:目的㊀以粘质沙雷氏菌为宿主菌,从河水中分离噬菌体,在体外和蚊虫肠道验证其裂解能力.方法㊀以粘质沙雷氏菌为宿主菌,在深圳周边河水中分离噬菌体,通过单㊁双层平板筛选单一的烈性噬菌体;利用噬斑形成实验验证噬菌体的裂解谱;通过饲喂实验验证噬菌体在埃及伊蚊肠道内的裂解作用.结果㊀从深圳河流污水中成功分离得到一株针对粘质沙雷氏菌的烈性噬菌体S H E N Z H E N 01,该噬菌体噬斑直径1mm 左右(培养10h ),边界清楚;对粘质沙雷氏菌S m 01㊁B a z 01具有明显的裂解能力,对其他粘质沙雷氏菌菌株㊁大肠杆菌㊁金黄色葡萄球菌㊁绿脓杆菌无裂解作用;对饲喂埃及伊蚊的粘质沙雷氏菌S m 01仍保持明显的裂解能力.结论㊀该噬菌体裂解作用具有特异性,而且在蚊虫肠道内仍能保持活性,具有可以用来治疗粘质沙雷氏菌引起的相关疾病的潜在价值.关键词:粘质沙雷氏菌;噬菌体;裂解;埃及伊蚊中图分类号:R 378.99㊀㊀㊀文献标识码:B ㊀㊀㊀文章编号:1002-2694(2021)04-0373-05I s o l a t i o na n d i d e n t i f i c a t i o no f ab a c t e r i o p h a ge f r o m S e r r a t i am a r c e s c e n s X I A O X i a o Gp i n g ,C H E N Y i Gl i n g,Z H A N G R e n Gl i (I n s t i t u t e o f P a t h o g e n i cO r g a n i s m s ,S h e n z h e nC e n t e r f o rD i s e a s eC o n t r o l a n dP r e v e n t i o n ,S h e n z h e n 518055,C h i n a )A b s t r a c t :S e r r a t i am a r c e s c e n s i sw i d e l y f o u n d i nw a t e r ,a n i m a l s a n d p l a n t f o o d s .W i t h t h e e m e r g e n c e o fm u l t i d r u gGr e s i s t Ga n t b a c t e r i a ,S e r r a t i am a r c e s c e n s i n f e c t i o n c a u s e s l u n g d i s e a s e a n du r i n a r y t r a c t i n f e c t i o n .P h a g e t h e r a p y fo r i n f e c t i o n s c a u s e d b y S e r r a t i am a r c e s c e n s i s a na l t e r n a t i v e o p t i o n .T o s t u d y t h e e f f e c t s o f p h a g e o n S e r r a t i am a r c e s c e n s ,w e i s o l a t e dab a c t e r i o Gp h a g e f r o ms e w a g e i n r i v e r s a r o u n dS h e n z h e n .As i n g l e s t r o n gp h a g ew a so b t a i n e d t h r o u g hs i n g l ea n dd o u b l e p l a t e s c r e e n i n g.T h ed i a m e t e r o f t h e p h a g e p l a q u ew a s a p p r o x i m a t e l y 1mm (c u l t u r e d f o r 10h ),a n d t h e b o u n d a r y w a s c l e a r .W e t e s t e d t h e l yGs a t e s p e c t r u mo f t h e p h a g ea n dv e r i f i e d i t s l y s i sa b i l i t y i nt h e i n t e s t i n eo f A e d e sa e g y p t i i na f e e d i n g e x p e r i m e n t .T h e p h a g e S H E N Z H E N 01h a da s t r o n g a b i l i t y t o l y s e S e r r a t i am a r c e s c e n s S m 01a n dB a z 01s t r a i n s ,b u t h a dn oe f f e c t o no t h e r S e r r a t i a m a r c e s c e n s s t r a i n s ,E s c h e r i c h i a c o l i ,S t a p h y l o c o c c u sa u r e u s a n d P s e u d o m o n a sa e r u gi n o s a .H o w e v e r ,p h a g eS H E N Z H E N 01w a s s t i l l a b l e t o l y s e S e r r a t i am a r c e s c e n s S m 01i n t h e i n t e s t i n e o f A e d e s a e g y pt i .T h e i s o l a t e db a c t e r i o p h a g e s s h o w e d s p e c i f i c c l e a v a g e a n d r e m a i n e da c t i v e i n v i v o ;t h e r e f o r e ,t h e y h a v e p o t e n t i a l v a l u e i n t h e t r e a t m e n t o f d i s e a s e s c a u s e d b y Se r r a t i am a r c Ge s c e n s .K e yw o r d s :S e r r a t i am a r c e s c e n s ;p h a g e ;l y s a t e ;A e d e s a e g y p t i S u p p o r t e db y aG r a n t f r o m N a t i o n a lN a t u r a l S c i e n c eF o u n d a t i o no fC h i n a (N o .31700148)a n dS h e n z h e nS a n GM i n g P r o j e c t f o r P r e v e n t i o na n dR e s e a r c ho nV e c t o r Gb o r n eD i s e a s e s (N o .S Z S M 201611064).C o r r e s p o n d i n g a u t h o r :Z h a n g R e n Gl i ,E m a i l :r e n l i z h a n g s z c d c @a l i yu n .c o m ㊀㊀粘质沙雷氏菌(S e r r a t i a m a r c e s c e n s )是一种腐生菌,在水和土壤中常见,也经常污染动㊁植物性食品[1].粘质沙雷氏菌是一种临床上常见的机会病原菌[2],医护人员被污染的手被认为是其主要的传播媒介[3G5].在机体免疫力低下的时候可以引起肺部感染㊁败血症等疾病[1,6G9].由于临床上抗生素的滥用和不合理使用,粘质沙雷氏菌对多种抗生素具有耐药,给感染控制和治疗带来挑战[10G11].除此之外,很多媒介昆虫的幼虫阶段生活在水中,粘质沙雷氏菌在这些昆虫的肠道中也大量存在,促进疾病传373播[6,12G14].噬菌体(P h a g e)是细菌内寄生生物,在自然界也是分布广泛.噬菌体侵染细菌后可以快速增殖并裂解宿主菌[15],目前临床上也有用噬菌体用于治疗的尝试[16].因此分离针对粘质沙雷氏菌的噬菌体对防治粘质沙雷氏菌感染具有潜在的应用价值.1㊀材料与方法1.1㊀材㊀料1.1.1㊀主要试剂和仪器㊀L B营养肉汤(028324,广东环凯微生物科技有限公司)㊁琼脂(028990,广东环凯微生物科技有限公司)㊁上层L B培养基(20g L B 营养肉汤加7g琼脂溶于1L蒸馏水)㊁下层L B培养基(20g L B营养肉汤加15g琼脂溶于1L蒸馏水)㊁全温振荡培养箱(S h e l l a b)㊁I I级A2型生物安全柜(T e l s t a rB i oGI IGA)㊁低温离心机(E p p e n d o r f c e n t r i f a g e5417R)㊁单孔水浴锅(J u L B O E DG27).1.1.2㊀实验用菌种㊀粘质沙雷氏菌(S m01㊁B a z01㊁C I C C22004㊁C GM C C1.2818㊁B N C C107931)㊁大肠杆菌(T H12641)㊁金黄色葡萄球菌(780)㊁绿脓杆菌(P s e u d o m o n a s s p.S QG7)均为实验室保存.1.2㊀噬菌体的分离和培养㊀取深圳某河边污水,4000r/m i n离心15m i n,用0.22μm的滤膜过滤除菌,将滤液装入无菌培养瓶.取4m L过滤后的上清,加入200μL的对数期宿主菌培养液,放置37ħ,220r/m i n培养箱培养3h,用微孔滤膜过滤得到噬菌体原液.1.3㊀噬菌体原液单层平板验证实验㊀准备两块1 5%L B琼脂平板,取宿主菌培养物100μL滴至平板正中央,用无菌的涂布棒将菌液均匀地涂开;待其晾干后,取上述噬菌体原液100μL滴于其中一块板,用无菌的涂布棒将液体均匀地涂开;待自然晾干后,置于37ħ培养箱培养10h.1.4㊀噬菌体双层平板噬菌斑实验㊀将噬菌体原液10-1㊁10-2㊁10-3㊁10-4㊁10-5㊁10-6倍比稀释,取相应的几个梯度的噬菌体稀释液各0.1m L与宿主菌液0.2m L充分混匀,铺双层琼脂平板,37ħ恒温培养10h左右,对每个琼脂平皿进行噬菌斑计数.根据稀释的倍数计算得到的噬菌体初始浓度即得噬菌体效价.在双层琼脂平板上挑取噬菌斑形状大小一致,单个独立的噬菌斑,用无菌的接种针穿刺选好的噬菌斑,接入3m LL B肉汤培养基,轻微搅拌几次,加入0.2m L含有粘质沙雷氏菌菌液,摇匀之后在室温静置1h,37ħ培养12h,4ħ下12000ˑg离心30m i n,用0.22μm的滤膜过去除菌,上清液4ħ保存,获得的单一噬菌体.1.5㊀噬菌谱实验㊀选择粘质沙雷氏菌的5个菌株和大肠杆菌㊁金黄色葡萄球菌㊁绿脓杆菌进行实验.准备1.5%L B琼脂平板,每组2块;取100μL细菌和100μL噬菌体混合,铺双层琼脂平板,对照组加入等量的P B S,置于37ħ培养箱培养10h.1.6㊀蚊虫肠道内裂解实验㊀埃及伊蚊(洛克菲勒株)饲养于低温照明培养箱,保持26ħ~28ħ恒温㊁80%湿度,按照文献标准方法进行饲养[17].选取羽化5~7d的雌性埃及伊蚊,首先给蚊虫饲喂含有抗生素的10%蔗糖溶液(20U青霉素㊁20m g链霉素/m L),连续饲喂3d,每24h更换.饲喂3d后将含有抗生素的蔗糖溶液撤走,在温度28ħ,湿度80%的条件下让其饥饿24h.然后饲喂带有粘质沙雷氏菌S m01的蔗糖溶液.连续饲喂3d.将上述蚊虫分成两组,其中一组只饲喂蔗糖溶液,另外一组饲喂添加了噬菌体S H E N Z H E N01(107P F U/m L)的蔗糖溶液.18h后每组挑选4~5只蚊虫进行实验.先用75%的乙醇溶液清洗蚊虫表面3次,无菌P B S清洗1次,接着在体视显微镜下解剖蚊虫的中肠,放入装有400μLP B S的无菌的E P管中,用无菌的研磨棒进行研磨,稀释103~105倍涂板,37ħ培养箱培养12h.2㊀结㊀果2.1㊀噬菌体平板验证和单一性筛选实验㊀在单层平板实验中,涂有菌液的区域长出均匀的粘质沙雷氏菌,涂有加入噬菌体菌液的区域没有菌落出现.由此判断,该噬菌体能够裂解粘质沙雷氏菌,而且噬菌体原液中含有滴度较高的烈性噬菌体(图1A).单一性噬菌体通过双层平板实验获得,噬菌斑经过多次穿刺培养后,分离得到单一的噬菌体,该噬菌体边缘清晰,噬斑直径约1mm(培养10h)(图1B),我们将该噬菌体命名为S H E N Z H E N01,保藏在广东省微生物菌种保藏中心,编号为61140.2.2㊀噬菌体裂解谱实验㊀进一步确认S H E N ZGH E N01噬菌体的裂解谱.我们首先选择粘质沙雷氏菌的5个菌株(S m01㊁B a z01㊁C I C C22004㊁C GMGC C1.2818㊁B N C C107931)进行双层平板实验,将噬菌体原液按照1ʒ1㊁1ʒ10㊁1ʒ100㊁1ʒ1000㊁1ʒ10000进行稀释,将噬菌体和粘质沙雷氏菌一起通过双层琼脂平板验证.结果发现S H E N Z H E N01噬菌体对S m01和B a z01有明显的裂解能力,对其他3株粘质沙雷氏菌没有裂解作用(图2A).另外,我们验证了S H E N Z H E N01噬菌体对其他种类细473中国人兽共患病学报2021,37(4)A :粘质沙雷氏菌噬菌体单层平板实验;B :噬菌体单一性筛选.图1㊀噬菌体噬斑实验F i g .1㊀S i n g l e l a y e r p l a t e p l a q u e f o r m a t i o n e x pe r i m e n t 菌的裂解能力,将噬菌体原液和粘质沙雷氏菌(S .m a r c e s c e n s )S m 01㊁大肠杆菌(E .c o l i )T H 12641㊁金黄色葡萄球菌(S .a u r e u s )780㊁绿脓杆菌(P .a e r u gi n o s a )S Q G7一起通过双层琼脂平板验证.结果表明,S H E N Z H E N 01噬菌体不能裂解大肠杆菌㊁金黄色葡萄球菌㊁绿脓杆菌(图2B ).这些结果表明噬菌体S H E N Z H E N 01的裂解作用有菌株特异性.2.3㊀蚊虫肠道内裂解实验㊀蚊虫经过消毒处理,取中肠研磨进行涂板计数.单独饲喂抗生素的蚊子(M o c k 组)中肠涂在L B 固体平板上几乎不长细菌,表明抗生素处理是成功的;饲喂了粘质沙雷氏菌S m 01的蚊子中肠涂板可见大量细菌生长,表明粘质沙雷氏菌S m 01可以在蚊子中肠成功定植(S e r r a Gt i a m a r c e s c e n s 组);而饲喂了噬菌体S H E N Z GH E N 01的蚊子中肠涂板几乎没有细菌生长(S e r r a Gt i am a r c e s c e n s +p h a ge 组),表明饲喂的噬菌体在蚊子体内也能裂解细菌(图3A ),通过平板计数显示饲喂了噬菌体的蚊子肠子中的粘质沙雷氏菌明显减少(图3B ),充分表明这个噬菌体在蚊虫体内也是有活性的,可以在体内裂解宿主细菌.A :5株粘质沙雷氏菌与不同稀释度的噬菌体混合涂双层琼脂平板;B :四种细菌分别和噬菌体混合涂双层琼脂平板图2㊀噬菌体裂解谱实验F i g .2㊀B a c t e r i o p h a g e l y s i s s pe c t r u m 3㊀讨㊀论粘质沙雷氏菌是临床上一种重要的条件致病菌[2],属于革兰氏阴性菌.在自然界,粘质沙雷氏菌在培养的时候呈现白色㊁粉红㊁玫瑰红3种颜色,我们采用的粘质沙雷氏菌来自于蚊虫肠道[14],呈现白色.粘质沙雷氏菌在临床上可以引起脑膜炎㊁肺部感染等疾病[6G9],耐药性的出现使这种菌很容易发生院内感染,对人的健康产生巨大威胁[10G11].噬菌体不会感染人,只感染特异的细菌,在水产养殖和耐药菌感染治疗方面具有光明的应用前景,越来越多的研究寻找特异性的噬菌体来解决细菌耐药的治疗问题[18].我们利用埃及伊蚊来源的粘质沙雷氏菌为宿主,从污水中分离得到1株噬菌体S H E N Z GH E N 01,通过单层平板实验就可以直接鉴定其裂解能力.由于噬菌体对细菌的裂解能力具有特异性和高效性.我们对噬菌体S H E N Z H E N 01的裂解谱进行了分析,发现S H E N Z H E N 01只对粘质沙雷氏菌S m 01和B a z 01有效,对其他3株粘质沙雷氏菌㊁大肠杆菌㊁金黄色葡萄球菌㊁绿脓杆菌均无裂解作用.粘质沙雷氏菌不仅可以定植到皮肤表面,也可以定植到肠道[2,14,19].由于动物或者昆虫体内环境5734期肖小平,等:1株粘质沙雷氏菌噬菌体的分离和鉴定A:蚊虫肠道内噬菌体裂解能力;B:蚊虫饲喂噬菌体后肠道粘质沙雷氏菌计数.M o c k组为饲喂含有抗生素的10%蔗糖溶液,3d后,只饲喂蔗糖溶液;S e r r a t i a m a r c e s c e n s组饲喂含有抗生素的10%蔗糖溶液,3d后,饲喂带有粘质沙雷氏菌S m01的蔗糖溶液,连续饲喂3d;S e r r a t i am a r c e s c e n s+p h a g e组为饲喂含有抗生素的10%蔗糖溶液,3d后,饲喂添加了噬菌体S H E N Z H E N01(107P F U/m L)的蔗糖溶液.18h后每组挑选4~5只蚊虫进行实验.图3㊀噬菌体在蚊虫肠道内裂解实验F i g.3㊀P h a g e l y s i s i nm o s q u i t o e s g u t与体外环境的差异,只有高效而且能够耐受体内环境的噬菌体才有可能走向应用,目前已经报道的痢疾噬菌体可以在体内应用于相关疾病的治疗[20].在这里,我们初步研究了噬菌体S H E N Z H E N01在蚊虫肠道内的裂解效果,结果表明该噬菌体在蚊虫肠道里仍然能够发挥裂解作用,这些研究为后续S H E N Z H E N01的应用提供重要的基础.噬菌体由于其感染的特异性,在水产养殖㊁耐药菌感染㊁院内特殊病房如烧伤感染等方面具有极大应用价值.噬菌体用于治疗也有本身的缺点,如噬菌谱窄㊁产生细菌耐药性㊁给药方式没有统一标准等[21].寻找更多的噬菌体,应用噬菌体鸡尾酒疗法是一个有效的办法[22].噬菌体在自然界具有多样性,种类繁多,国家层面也需要加大对噬菌体治疗的基础研究投入,建成全国性甚至世界性的噬菌体库,资源共享,噬菌体治疗的价值才能显现出来.利益冲突:无引用本文格式:肖小平,陈依玲,张仁利.1株粘质沙雷氏菌噬菌体的分离和鉴定[J].中国人兽共患病学报,37(4):373G377.D O I:10.3969/j.i s s n.1002G2694.2021.00.039参考文献:[1]A b r e oE,A l t i e rN.P a n g e n o m eo f S e r r a t i a m a r c e s c e n s s t r a i n s f r o m n o s o c o m i a la n d e n v i r o n m e n t a lo r i g i n s r e v e a l s d i f f e r e n t p o p u l a t i o n s a n d t h e l i n k sb e t w e e nt h e m[J].S c iR e p,2019,9(1):46.D O I:10.1038/s41598G018G37118G0[2]M o l e s L,Góm e zM,M o r o d e r E,e t a l.S e r r a t i am a r c e s c e n s c o lGo n i z a t i o ni n p r e t e r m n e o n a t e sd u r i n g t h e i rn e o n a t a li n t e n s i v e c a r eu n i t s t a y[J].A n t i m i c r o bR e s i s t I n f e c tC o n t r o l,2019,8:135.D O I:10.1186/s13756G019G0584G5[3]A r s l a nU,E r a y m a n I,K i r d a r S.e t a l.S e r r a t i am a r c e s c e n s s e pGs i s o u t b r e a k i nan e o n a t a l i n t e n s i v ec a r eu n i t[J].P e d i a t r I n t,2010,52:208G212.D O I:10.1111/j.1442G200X.2009.02934.x [4]C a s o l a r iC,P e c o r a r iM,F a b i oG,e ta l.As i m u l t a n e o u so u tGb r e a ko f S e r r a t i a m a r c e s c e n s a n d K l e b s i e l l a p n e u m o n i a e i na n e o n a t a l i n t e n s i v e c a r e u n i t[J].JH o s p I n f e c t,2005,61:312G320.D O I:10.1016/j.j h i n.2005.03.005[5]J a n g T N,F u n g C P,Y a n g T L,e t a l.U s eo f p u l s e dGf i e l d g e l eGl e c t r o p h o r e s i s t o i n v e s t i g a t e a no u t b r e a ko f S e r r a t i am a r c e s c e n s i n f e c t i o n i nan e o n a t a l i n t e n s i v ec a r eu n i t[J].J H o s p I n f e c t,2001,48:13G19.D O I:10.1053/j h i n.2001.0947[6]C r i s t i n aM L,S a r t i n iM,S p a g n o l oAM.S e r r a t i am a r c e s c e n s i nGf e c t i o n s i n N e o n a t a l I n t e n s i v eC a r e U n i t s(N I C U s)[J].I n tJ E n v i r o nR e sP u b l i cH e a l t h,2019,16(4):610.D O I:10.3390/ i j e r p h16040610[7]B a y r a m o g l uG,B u r u kK,D i n cU,e t a l.I n v e s t i g a t i o n o f a n o u tGb r e a ko f S e r r a t i a m a r c e s c e n s i nan e o n a t a l i n t e n s i v ec a r eu n i t [J].JM i c r o b i o l I mm u n o l I n f e c t,2011,44(2):111G115.D O I:10.1016/j.j m i i.2010.02.002[8]S a r a l e g u i C,P o n c eGA l o n s oM,Pér e zGV i s oB,e t a l.G e n o m i c s o f S e r r a t i a m a r c e s c e n s i s o l a t e s c a u s i n g o u t b r e a k s i n t h e s a m e p e d iGa t r i c u n i t47y e a r s a p a r t:p o s i t i o n i n a n u p d a t e d p h y l o g e n y o f t h e s p e c i e s[J].F r o n t M i c r o b i o l,2020,11:451.D O I:10.3389/ f m i c b.2020.00451[9]朱梅英,顾华芳,戴芸,等.新生儿粘质沙雷菌败血症21例临床分析[J].中华新生儿科杂志,2018,33(5):321G324.D O I:10.3760/c m a.j.i s s n.2096G2932.2018.05.001673中国人兽共患病学报2021,37(4)[10]L i o uB H,D u hRW,L i nY T,e t a l.A m u l t i c e n t e r s u r v e i l l a n c e o f a n t i m i c r o b i a lr e s i s t a n c ei n S e r r a t i a m a r c e s c e n s i n T a i w a n [J].JM i c r o b i o l I mm u n o l I n f e c t,2014,47(5):387G393.D O I:10.1016/j.j m i i.2013.04.003[11]陈国华.2013-2017年苏州某院分离的粘质沙雷菌流行状况及耐药情况分析[D].南京:南京医科大学,2018.[12]刘九榕,邵博文,周宇石,等.一株沙雷氏菌的分离鉴定及其对德国小蠊的毒力测定[J].生物学通报,2019,54(3):50G52.D O I:10.3969/j.i s s n.0006G3193.2019.03.019[13]傅仁杰,祁雪连,丰凯,等.一株分离自黑翅土白蚁的粘质沙雷氏菌的鉴定及特性[J].南京林业大学学报(自然科学版),2019,1:76G82.D O I:10.3969/j.i s s n.1000G2006.201804003[14]W uP,S u nP,N i eK,e t a l.AG u t C o mm e n s a l B a c t e r i u mP r oGm o t e sM o s q u i t oP e r m i s s i v e n e s s t oA r b o v i r u s e s.C e l lH o s tM iGc r o b e[J].2019,25(1):101G112.e5.D O I:10.1016/j.c h o m.2018.11.004[15]C a i r n s B J,P a y n eR J.B a c t e r i o p h a g e t h e r a p y a n d t h em u t a n t s eGl e c t i o nw i n d o w[J].A n t i m i c r o b A g e n t sC h e m o t h e r,2008,52(12):4344G4350.D O I:10.1128/A A C.00574G08[16]M a l i k D J,S o k o l o vI J,V i n n e rG K,e ta l.F o r m u l a t i o n,s t aGb i l i s a t i o n a n d e n c a p s u l a t i o no f b a c t e r i o p h a g e f o r p h a g e t h e r a p y[J].A d vC o l l o i d I n t e r f a c eS c i,2017,249:100G133.D O I:10.1016/j.c i s.2017.05.014[17]X i a oX,L i uY,Z h a n g X,e t a l.C o m p l e m e n tGr e l a t e d p r o t e i n s c o n t r o l t h ef l a v i v i r u s i n f e c t i o no f A e d e sa e g y p t i b y i n d u c i n g a n t i m i c r o b i a l p e p t i d e s[J].P L o S P a t h o g,2014,10(4): e1004027.D O I:10.1371/j o u r n a l.p p a t.1004027[18]R e h m a nS,A l i Z,K h a n M,e t a l.T h e d a w no f p h a g e t h e r a p y.R e v M e dV i r o l,2019,29(4):e2041.D O I:10.1002/r m v.2041[19]R a y m a n nK,C o o nK L,S h a f f e r Z,e t a l.P a t h o g e n i c i t y o f S e rGr a t i am a r c e s c e n s S t r a i n s i n H o n e y B e e s[J].m B i o,2018,9(5):e01649G18.D O I:10.1128/m B i o.01649G18[20]丛聪,魏炳栋,袁玉玉,等.上世纪50年代中国噬菌体研究成就回顾及思索[J].国外医药(抗生素分册),2019,40(5):401G409.[21]C a f l i s c hKM,S u hG A,P a t e lR.B i o l o g i c a l c h a l l e n g e s o f p h a g e t h e r a p y a n d p r o p o s e d s o l u t i o n s:a l i t e r a t u r e r e v i e w[J].E x p e r t R e vA n t i I n f e c tT h e r,2019,17(12):1011G1041.D O I:10.1080/14787210.2019.1694905[22]C h a nB K,A b e d o nS T,L o cGC a r r i l l oC.P h a g e c o c k t a i l s a n d t h e f u t u r e o f p h a g et h e r a p y[J].F u t u r e M i c r o b i o l,2013,8(6):769G783.D O I:10.2217/f m b.13.47收稿日期:2020G07G27㊀编辑:王晓欢(上接第372页)[37]K o lA,S u k h o v aG K,L i c h t m a n A H,e ta l.C h l a m y d i a lh e a t s h o c k p r o t e i n60l o c a l i z e si n h u m a na t h e r o m aa n dr e g u l a t e s m a c r o p h a g et u m o rn e c r o s i sf a c t o rGa l p h aa n d m a t r i x m e t a l l oGp r o t e i n a s e e x p r e s s i o n[J].C i r c u l a t i o n,1998,98(4):300G307.D O I:10.1161/01.c i r.98.4.300[38]N e t e aM G,S e l z m a nC H,K u l l b e r g B J,e t a l.A c e l l u l a r c o m p oGn e n t so f C h l a m y d i a p n e u m o n i a e s t i m u l a t e c y t o k i n e p r o d u c t i o n i nh u m a nb l o o dm o n o n u c l e a r c e l l s[J].E u r J I mm u n o l,2000,30(2):541G549.D O I:10.1002/1521G4141(200002)30:2<541::A I DGI MMU541>3.0.C O;2GX[39]L i B,X i aY,H uB.I n f e c t i o n a n d a t h e r o s c l e r o s i s:T l rGd e p e n dGe n t p a t h w a y s[J].C e l l M o lL i f eS c i,2020:1G19.D O I:10.1007/s00018G020G03453G7[40]D o y l eB,C a p l i c eN.P l a q u en e o v a s c u l a r i z a t i o na n da n t i a n g i oGg e n i c t h e r a p y f o r a t h e r o s c l e r o s i s[J].JA mC o l l C a r d i o l,2007,49(21):2073G2080.D O I:10.1016/j.j a c c.2007.01.089[41]F a z i o G,G i o v i n o M,G u l l o t t iA,e ta l.A t h e r o s c l e r o s i s,i nGf l a mm a t i o na n d C h l a m y d i a p n e u m o n i a e[J].W o r l d JC a r d i o l,2009,1(1):31G40.D O I:10.4330/w j c.v1.i1.31[42]E s e n w aC C,E l k i n d M S.I n f l a mm a t o r y r i s kf a c t o r s,b i o m a r kGe r s a n da s s o c i a t e dt h e r a p y i ni s c h a e m i cs t r o k e[J].N a tR e vN e u r o l,2016,12(10):594G604.D O I:10.1038/n r n e u r o l.2016.125[43]L u c c h e s eG,F l o e lA,S t a h l B.C r o s sGr e a c t i v i t y a s am e c h a n i s m l i n k i n g i n f e c t i o n s t os t r o k e[J].F r o n tN e u r o l,2019,10:469.D O I:10.3389/f n e u r.2019.00469收稿日期:2020G05G20㊀编辑:王晓欢7734期肖小平,等:1株粘质沙雷氏菌噬菌体的分离和鉴定。

噬菌体的分离及其寄主细胞的鉴定噬菌体是一种寄生于细菌的病毒,其存在的意义在于调节细菌数量,维持生态平衡。
与其他病毒不同的是,噬菌体的寄主是细菌,而细菌则作为噬菌体的繁殖基质。
因此,了解噬菌体的分离及其寄主细胞的鉴定对于维持微生物群落的稳定,维护人类健康具有重要意义。
一、噬菌体的分离方法噬菌体可以通过两种方法分离:(1)寄主膜破碎法;(2)巨细胞法。
寄主膜破碎法是最常用的噬菌体分离方法,其原理为化学溶解寄主菌的细胞壁和膜,使得噬菌体被释放。
该方法的具体步骤为:(1)将寄主菌接种到培养皿中;(2)加入一定浓度的化学物质,如Tween 80、SDS等,使得细胞壁和膜溶解;(3)离心沉淀,去除寄主菌留下噬菌体。
巨细胞法是一种体外培养细胞法,其原理为在营养缺乏的培养液中,将噬菌体感染到寄主细胞并使其增殖,形成巨细胞,最终分离出噬菌体。
该方法的具体步骤为:(1)通过定量PCR或滴定法测定噬菌体的初始含量;(2)将噬菌体感染到与其适宜的寄主细胞上,培养到合适的时间,直至形成巨细胞;(3)收集巨细胞,离心沉淀,分离出噬菌体。
二、寄主细胞的鉴定方法寄主细胞的鉴定是噬菌体研究中非常关键的一步。
它不仅可以确定噬菌体的寄主范围,还可以研究噬菌体与细菌之间的相互作用和生态响应。
常用的寄主细胞鉴定方法有三种:(1)凝胶探针法;(2)PCR法;(3)无基因片段标记法。
凝胶探针法是一种经典的寄主细胞鉴定方法,其原理为将寄主菌接种到寒暖交替的凝胶中,凝胶中形成的细胞克隆呈现不同的形态,通过寻找与噬菌体作用的细胞克隆,识别寄主细胞。
该方法虽然准确性较高,但需要大量耗时和耗材,难以大量应用。
PCR法是一种简便快速的寄主细胞鉴定方法,其原理为针对细胞壁或内质网上的基因间隔区,设计特异的引物,进行PCR扩增,通过扩增产物的测序或分子量鉴别寻找寄主细胞。
该方法的优势在于对样品的要求低,检测速度快,能够大量应用。
无基因片段标记法是一种新型的寄主细胞鉴定方法,其原理为将受噬菌体感染的细胞进行荧光标记或电化学标记,利用仪器检测关键生化分子的变化,直接寻找寄主细胞。

1. 学习噬菌体的分离方法。
2. 掌握噬菌体纯化技术。
3. 了解噬菌体形态和生物特性的观察。
二、实验原理噬菌体是一种感染细菌的病毒,具有高度的特异性。
噬菌体分离实验是通过在含有细菌的培养基上加入噬菌体,观察噬菌体对细菌的裂解作用,从而分离出纯化的噬菌体。
三、实验材料1. 实验组:大肠杆菌(Escherichia coli)菌种、噬菌体培养液、琼脂平板、无菌镊子、无菌滴管等。
2. 对照组:大肠杆菌菌种、无菌水、琼脂平板、无菌镊子、无菌滴管等。
四、实验步骤1. 制备培养基:将大肠杆菌菌种接种于牛肉膏蛋白胨培养基,37℃培养18小时。
2. 分离噬菌体:取一定量的噬菌体培养液,加入适量的无菌水进行稀释,取一定量的稀释液加入琼脂平板中,轻轻摇匀。
3. 制备平板:将制备好的培养基倒入平板中,待凝固后,用无菌镊子取适量的大肠杆菌菌液均匀涂布在平板表面。
4. 孵育平板:将平板倒置,37℃恒温培养24小时。
5. 观察结果:观察平板上的菌落,找出裂解斑,即噬菌体感染后的菌落。
6. 纯化噬菌体:用无菌镊子夹取裂解斑边缘的菌落,接种于新的琼脂平板中,37℃恒温培养24小时。
7. 观察纯化结果:观察平板上的菌落,若出现单菌落,则表明噬菌体已纯化。
8. 观察噬菌体形态和生物特性:将纯化的噬菌体培养液置于透射电镜下观察,观察噬菌体的形态。
同时,进行噬菌体的吸附实验、裂解实验等,了解噬菌体的生物特性。
1. 分离噬菌体:平板上出现裂解斑,表明噬菌体已成功分离。
2. 纯化噬菌体:平板上出现单菌落,表明噬菌体已纯化。
3. 噬菌体形态:透射电镜下观察到噬菌体呈长圆柱形,具有尾丝。
4. 噬菌体生物特性:吸附实验和裂解实验均表明噬菌体具有感染大肠杆菌的能力。
六、实验讨论1. 实验过程中,要注意无菌操作,避免污染。
2. 噬菌体分离实验的关键是裂解斑的观察,裂解斑的出现表明噬菌体已成功分离。
3. 噬菌体纯化过程中,要注意纯化程度的判断,避免杂菌污染。

铜绿假单胞菌噬菌体的分离鉴定及其基因组学研究铜绿假单胞菌(Pseudomonas aerugonosa)在医学上称为绿脓杆菌。
该菌具有极强的环境适应能力和对多种抗生素的耐受能力。
对于人体,绿脓杆菌是最重要的条件致病菌,是创伤、烧伤及免疫受损机体最容易感染的细菌之一,严重地危害着人类的健康与生命。
噬菌体(Bacteriophage)是细菌的病毒,它与宿主菌关系密切。
一方面,溶原性噬菌体通过自身携带的外源性遗传物质改变宿主菌的生物学性状,同时,在与宿主菌基因组不断地重组、整合、转座和切离过程中彼此交换遗传物质,影响宿主菌及自身基因的多样性,成为除质粒之外的一股重要基因流(genestream),在生物之间介导着基因的水平转移(horizontal transfer);另一方面,基于裂菌性噬菌体能特异性裂解宿主菌,也基于如果诱导前噬菌体进入裂菌性生长周期就可导致细菌裂解,噬菌体有望发展成为抗细菌感染的生物制剂。
不管是想研究噬菌体与细菌间相互作用关系,揭示噬菌体介导的基因水平转移所导致的生物多样性等重大问题,还是研究噬菌体的工程改造和噬菌体治疗,都需要对噬菌体及其宿主菌的遗传学背景有极清楚的认识。
最近,绿脓杆菌PA01菌株全基因组测序工作已完成,而绿脓杆菌噬菌体的基因组研究工作的积累仍非常有限。
为此,本研究以绿脓杆菌为宿主菌,成功分离了3株新的噬菌体,对其中两株(一为溶原性噬菌体,一为裂菌性噬菌体,二者具有一相同的宿主菌)展开了全基因组测序。
井对已完成测序的PaP3展开了基因组学研究和某些基因功能的研究。
主要内容及实验结果包括以下几方面: 1.以绿脓杆菌临床分离株为宿主菌,从医院下水道污水中分离到3株绿脓杆菌噬菌体,分别命名为 PaPI、PaPZ和 PaP3。
其中 PaPI是裂菌性噬菌体,PaPZ和PaP3是溶原性噬菌体;电镜结果表明PaPI为有尾噬菌体,PaPZ、PaP3为短尾噬菌体;按国际上分类标准,PaPI属肌尾噬茵体科m),PaPZ和PaP3属短尾噬菌体科(Pedoviridae);三株均为双链DNA噬菌体。

浅谈酸奶发酵过程中噬菌体的分离及其特性作者:吕宇蓓来源:《赢未来》2018年第26期摘要:随着乳制品行业的发展,酸奶的功能逐渐被更多的人重视,酸奶的发酵过程是十分严谨的,在发酵过程中,乳酸菌极易受到噬菌体的侵染,导致酸奶出现质量问题,所以现阶段急需对噬菌体进行分离和特性研究,在高中课堂上,我们已经学习了噬菌体的分离方法。
本文主要对酸奶制造过程中噬菌体的分离步骤进行探讨,并分析噬菌体的特有性质。
关键词:酸奶发酵;噬菌体特性1 噬菌体概述为了使我们对噬菌体的特性有初步了解,高中生物课本对噬菌体有详细的介绍,噬菌体是一种能够侵染细菌、真菌以及藻类的病毒,它是不能单独生存的,必须依靠汲取宿主细胞的营养物质进行自身能量的供给,在细菌群落和细菌聚集的地方经常有噬菌体的出现。
噬菌体的体积较小,分类方法比较复杂,在生物课堂上,教师也对噬菌体的特性进行了介绍,噬菌体的结构相对较为简单,没有独立完整的细胞结构,只具有一种核酸类型,对细菌和真菌的侵染效果特别明显[1]。
2 酸奶发酵过程中噬菌体的分离步骤2.1.将指示菌种进行活化并过滤为了更准确的探讨噬菌体的特性,应该对酸奶进行噬菌体的检测,故首先要进行检测指示菌的培养,在高中生物实验中以乳杆菌中噬菌体的分离为例,将作为指示菌株的乳杆菌放置在37℃的培养液培养至少24小时,使菌株保持活性,接着采用0.4μm的纯净过滤膜将酸奶样品进行过滤,将其它会干扰实验的细菌除去,从而能够使得噬菌体的检测结果更加精确[2]。
2.2选用适当培养基使噬菌斑出现在高中课本上对乳杆菌的培养基进行了大致介绍,本次分离实验采用的乳杆菌培养基的形式是固体与半固体相混合,经过活化和过滤的指示菌与样品酸奶的加入比例是1:1000,教师在授课过程中提到1ml样品酸奶的量较为适宜,在指示菌和培养基的共同作用下,大约24h 后,噬菌斑会出现在培养基中,接下来需要我们对噬菌斑进行观察,达到一定量才能进行下一步实验。

大肠杆菌发酵中强裂解性噬菌体的分离和鉴定陈江坡;程江红;康培;刁刘洋【摘要】:噬菌体在自然界中种类很多,在细菌发酵的工业生产中极易感染噬菌体.从工业苏氨酸生产菌(大肠杆菌M G1655来源)的培养液中分离到一株裂解能力强大的噬菌体,分析其生物学特性并鉴定其种类能够为以后抗性菌株的制备和防止再次感染提供研究基础.采用双层琼脂平板法分离、纯化噬菌体,观察噬菌斑特征,通过电镜观察噬菌体形态特征.分离、纯化获得一株能高效裂解大肠杆菌M G1655的噬菌体.噬菌斑呈圆形、大而透明、边缘整齐.电镜观察噬菌体的头部呈二十面体立体对称,尾部较长.酶切鉴定结果表明噬菌体的核酸类型为dsDNA,确定其属于有尾噬菌体目长尾噬菌体科成员,命名为M HV4.分离鉴定了一株裂解效率极高的大肠肝菌MG1655噬菌体,并确认其为长尾噬菌体科成员,为后续抗噬菌体菌株的筛选和改造奠定基础,并为苏氨酸工业生产提供保障.【期刊名称】《发酵科技通讯》【年(卷),期】2018(047)004【总页数】4页(P209-211,248)【关键词】噬菌体;大肠杆菌MG1655;苏氨酸;生物学特性【作者】陈江坡;程江红;康培;刁刘洋【作者单位】廊坊梅花生物技术开发有限公司,河北廊坊 065001;梅花生物科技集团股份有限公司,河北廊坊 065001;廊坊梅花生物技术开发有限公司,河北廊坊065001;梅花生物科技集团股份有限公司,河北廊坊 065001;梅花生物科技集团股份有限公司,河北廊坊 065001;梅花(上海)生物科技有限公司,上海 201203;廊坊梅花生物技术开发有限公司,河北廊坊 065001;梅花生物科技集团股份有限公司,河北廊坊 065001;梅花(上海)生物科技有限公司,上海 201203【正文语种】中文【中图分类】TQ92噬菌体是一类普遍存在于自然界中的感染细菌并在细菌内完成复制的病毒,数量是细菌的10倍以上[1]。
病理学家Twort和微生物学家D’Herelle在1915年和1917年分别独立发现了噬菌体[2]。
现代农业科技2021年第8期动物科学摘要噬菌体具有特异性强、无残留、对人畜无感染性、容易筛选获得等独特优势,在无抗养殖趋势下潜力巨大。
本研究从鸡场采集粪便样本,从中分离出大肠杆菌,再从粪便样本中分离、纯化出噬菌体,测定纯化后噬菌体的效价,并对噬菌体的噬菌谱进行研究。
结果表明:噬菌体可以裂解大肠杆菌;分离到的噬菌体为宽宿主谱噬菌体,但有一定的局限性。
关键词噬菌体;大肠杆菌;宿主谱中图分类号S859.1文献标识码A 文章编号1007-5739(2021)08-0183-04DOI :10.3969/j.issn.1007-5739.2021.08.078开放科学(资源服务)标识码(OSID ):Study on Isolation of Escherichia coli Bacteriophage and Its Host SpectrumXU Fangfang 1JIAO Li 2*LI Fenghua 1WANG Yuxia 1LIN Zhiyu 3(1Shandong Xundakang Veterinary Medicine Co.,Ltd.,Jinan Shandong 250316;2Animal Husbandry and Veterinary Department of Cangzhou Polytechnic College,Cangzhou Hebei 061000;3Yantai Tianhua Breeding Co.,Ltd.,Yantai Shandong 264000)Abstract Bacteriophage has the unique advantages of strong specificity,no residue,no infection to human and livestock,easy to screen and so on,which has great potential in the absence of anti breeding trend.In this study,we collected fecal samples from chicken farms,isolated E.coli from them,and then isolated and purified bacteriophages from fecal samples,determined the titer of purified bacteriophages,and studied the bacteriophage spectrum.The results showed that bacteriophage could cleave E.coli ,and bacteriophage isolated had a wide host spectrum,but it had some limitations.Keywords bacteriophage;Escherichia coli ;host spectrum大肠杆菌噬菌体分离及宿主谱研究许方方1焦莉2*李凤华1王玉霞1林治钰3(1山东迅达康兽药有限公司,山东济南250316;2沧州职业技术学院畜牧兽医系,河北沧州061000;3烟台天华饲养有限公司,山东烟台264000)大肠杆菌(Escherichia coli )是健康畜禽肠道中正常存在的菌种,可分为致病性和非致病性2类。
大肠埃希氏杆菌噬菌体的分离与纯化【实验目的】1.培养自主查阅资料,自行设计、整理实验方案,自己安排实验的能力。
2.通过综合性大实验进一步掌握微生物实验的基本原理和技术、培养无菌意识。
3.培养互助协作的团队精神和分析解决问题的能力。
4.掌握从污水中分离和纯化大肠埃希氏菌噬菌体的原理。
5.掌握噬菌体的分离与纯化以及用双层琼脂平板法培养噬菌体的方法。
【实验原理】1.凡有寄主细胞存在的地方,一般都能找到其相应的噬菌体。
粪便和阴沟污水等往往是各种肠道细菌尤其是大肠杆菌的栖居地,故常能从其中分离到各肠杆菌噬菌菌株的相应噬菌体。
2.从自然界分离某一噬菌体的一般方法是:(1)培养寄主细胞(大肠杆菌);(2)采集含有相应寄主细胞的噬菌体(阴沟污水);(3)将样品内的细胞进行富集培养;(4)制备噬菌体裂解液;(5)检测噬菌体是否存在;(6)噬菌体的纯化及效价测定。
3.培养基的配制(配方)与灭菌(1)3×牛肉膏蛋白胨培养液:牛肉膏9克,蛋白胨30克,NaCl 15克,自来水1000ml,Ph 7.2-7.4.(2)牛肉膏蛋白胨培养液:牛肉膏3克,蛋白胨10克,NaCl 5克,自来水1000ml,Ph 7.2-7.4.(3)牛肉膏蛋白胨固体培养基:牛肉膏3克,蛋白胨10克,NaCl 5克,琼脂条20克,自来水1000 ml,Ph 7.2-7.4。
(4)牛肉膏蛋白胨琼脂半固体培养基:牛肉膏3克,蛋白胨10克,NaCl 5克,琼脂条7克,自来水1000ml,Ph 7.2-7.4。
封好做好标记于121℃灭菌20min备用【实验材料及器皿】1.菌种:大肠埃希氏菌。
2.噬菌体样品:矛坡的阴沟污水3.培养基:3×牛肉膏蛋白胨培养液,牛肉膏蛋白胨培养液,牛肉膏蛋白胨琼脂培养基,牛肉膏蛋白胨琼脂半固体培养基。
4.仪器:离心机,恒温水浴锅,冰箱,恒温培养箱,高压灭菌锅,酒精灯,量筒,微量移液器及枪头,火柴,接种针,标记笔,无菌涂布棒,培养皿,试管,三角瓶,电热炉,玻璃棒,牛皮纸,纱布,PH试纸,橡皮筋。
噬菌体的分离和鉴定部分菌株对应的噬菌体分离过程步骤:1、噬菌体分离(1) 以新鲜鸽粪4g 加入100ml 普通液体培养基内,放入37 ℃温箱培养24h。
(2) 次日从中取出10ml70 ℃加热30min ,离心2000r/ 10min ,上清液用滤器过滤后保存于4 ℃冰箱备用。
(3) 在普通琼脂平板底面分别注明1、2、3 号。
(4)在1 号平板接种事先培养好的6h 幼龄菌乙型副伤寒杆菌一接种环;2 号平板接种幼龄菌福氏痢疾杆菌一接种环;3 号平板接种幼龄菌大肠杆菌一接种环,各平板的细菌密集涂布于琼脂平板表面。
(5) 再用无菌接种环取鸽粪培养滤液一接种环,分别滴加于3 个已接种细菌的平板中央,放入37 ℃温箱孵育24h。
2、噬菌体的分离和鉴定先后从农贸市场采集各类海产品158 份, 分别用15 株假单胞菌作指示菌, 共分离到27 株噬菌体, 分离率为1711%。
检出的噬菌体经实验室反复增殖、裂解等鉴定试验, 从中精选出9 株裂解力较强, 生物学性状较典型的噬菌体, 分别用双层琼脂法作单斑纯化培养。
这9 株噬菌体的噬菌斑圆形透明, 边缘有的整齐有的稍不整齐, 直径均在110~21 0 mm; 在电镜下的形态可见有头部和尾部, 均呈蝌蚪状; 增殖液的效价均可达10829pf uˆm l。
3、噬菌体的分离在有指示菌的双层琼脂平板上逐格滴加备用的待检噬菌体液,进行交叉裂解试验,即每一株菌均被所有待检噬菌体液逐一滴加。
待平皿干后,置37 ℃培养过夜。
若有相应的噬菌体存在,即可在平皿上出现裂解噬斑(即为阳性) ,不裂解者为阴性。
对分离到的每一噬菌体均经单噬斑分离纯化3 次以上,增殖后置4 ℃冰箱保存。
4、大连近海河流弧菌Ⅱ噬菌体的分离与研究4.1 材料与方法4.2 菌株噬菌体分离所用的指示菌为河流弧菌29301 , 用于宿主范围测定的菌株共8 株: 河流弧菌Ⅱ9302 , 9401 , 9402 , 9403 , 9404 , 9501 , 9502 及9503 均为本实验室保存。
变形杆菌(大肠杆菌)噬菌体生理特性研究
1.变形杆菌、大肠杆菌的纯化
划线分离纯化
2. 变形杆菌噬菌体、大肠杆菌噬菌体分离
器材:
菌种:变形杆菌、大肠杆菌
噬菌体样品:阴沟污水(100ml),土壤
培养基:3倍牛肉膏蛋白胨培养液(4瓶,每瓶50ml),牛肉膏培养液,牛肉膏蛋白胨半固体培养基(倒上层用),牛肉膏蛋白胨琼脂培养基(倒底层用)
仪器:离心机,细菌滤器,抽滤装置,恒温水浴锅,无菌涂布器,无菌吸管等
步骤:
a.培养大肠杆菌至对数期600nm(OD值0.8左右)
b.增殖噬菌体样品:取上述大肠杆菌培养液6ml于盛有50ml 3倍牛肉膏蛋白胨培养液的三角瓶内,后加入污水样100ml(离心并过滤除菌),继续37℃摇床振荡培养12-14h,以增殖噬菌体。
c.制备裂解液:将以上培养液3000r/min离心30min,将上清液过滤除菌,取100ml 滤液及5ml大肠杆菌液加入50ml 3倍牛肉膏蛋白胨培养液中,37℃培养12-18h 进行噬菌体富集。
d.将以上富集液3000r/min离心30min后,取上清液10mL加入5mL 3×倍牛肉膏蛋白胨培养液及相应宿主菌液1mL,室温下放置1h,37℃ 120rpm振荡培养 3.5h。
e.收集噬菌体:将上述培养液于4℃下12,000g 离心30min,上清液再经微孔滤膜(0.22μm)过滤,滤液即为拟含有相应宿主菌噬菌体的原液。
f.验证噬菌体存在:在大肠杆菌平板上,滴加上述滤液5-7小滴,同时滴加生理盐水作为对照,进行标记,37℃培养18-20h,若出现噬菌斑,则证明滤液中存在噬菌体。
3. 变形杆菌噬菌体、大肠杆菌噬菌体纯化
(1)用接种环取菌液一环接种于液体培养基内,再加人0.1ml大肠杆菌悬液,使混合均匀。
(2)取上层琼脂培养基,溶化并冷至48℃(可预先溶化、冷却,放48℃水溶箱内备用),加入以上噬菌体与细菌的混合液0.2ml,立即混匀,并立即倒人底层培养基上,混匀,置37℃培养12h。
(3)此时长出的分离的单个噬菌斑,其形态、大小常不一致,再用接种针在单个噬菌斑中刺一下,小心采取噬菌体,接入含有大肠杆菌的液体培养基内。
于37℃
培养。
(5)等待管内菌液完全溶解后,过滤除菌,即得到纯化的噬菌体。
4.噬菌体最佳感染复数的测定
培养宿主菌至对数前期,用分光光度计( BIO-RAD) 测定其A600值=0.2,相当于1*108 CFU/ ml。
按照感染复数分别为10-4、10-3、10-2、10-1、100和101的比例加入噬菌体,混匀,37℃震荡培养5 h,10000 g 离心10 min,收集上清测定噬菌体滴度。
以上均作双份复管培养,取平均值,同时设空白对照,以产生最高噬菌体滴度的MOI (multiplicity of infection)为最佳感染复数。
注:感染复数:指感染时噬菌体与细菌的数量比值,即平均每个细菌感染噬菌体的数量。
5. 噬菌体一步生长曲线
将噬菌体及宿主菌按MOI= 10 混合,37℃温育15 min后10000 g离心30s,弃上清;LB液洗涤2次,用5 ml预热的LB液混悬沉淀并充分混匀,置于37℃振荡培养,并开始计时,于0时刻和每隔10 min取样50微升,13000g离心30s,吸取上清测定噬菌体滴度。
各时间点均做双份复管,取平均值,同时设空白对照,重复3 次。
最后以感染时间为横坐标,感染体系中噬菌体的滴度为纵坐标,绘制一步生长曲线,计算噬菌体的潜伏期、爆发期和爆发量。